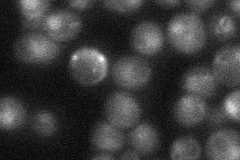
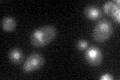

View description
Protein containing zinc fingers, involved in repression, along with Mig1p, of SUC2 (invertase) expression by high levels of glucose; binds to Mig1p-binding sites in SUC2 promoter
Localization:
Intensity:
Fold change:
Significance:
-
C’ GFP library in SD

nucleus29.68 -
N' NOP1pr-GFP in SD

cell periphery,nucleus21.2117 -
N' TEF2pr-mCherry in SD

nucleus5.95579 -
N' NATIVEpr-GFP in SD
nucleus27.0993 -
N' TEF2pr-VC and Cyto-VN in SD

#N/A0 -
C’ GFP library in SD+DTT

nucleus36.061.21No -
C’ GFP library in SD+H2O2

nucleus30.791.03No -
C’ GFP library in Starvation Media
nucleus40.821.37Yes -
C’ GFP library on the background of Pup2-DaMP

nucleus -
C’ GFP library on the background of CCT mutant

nucleus37.45331.26153No
